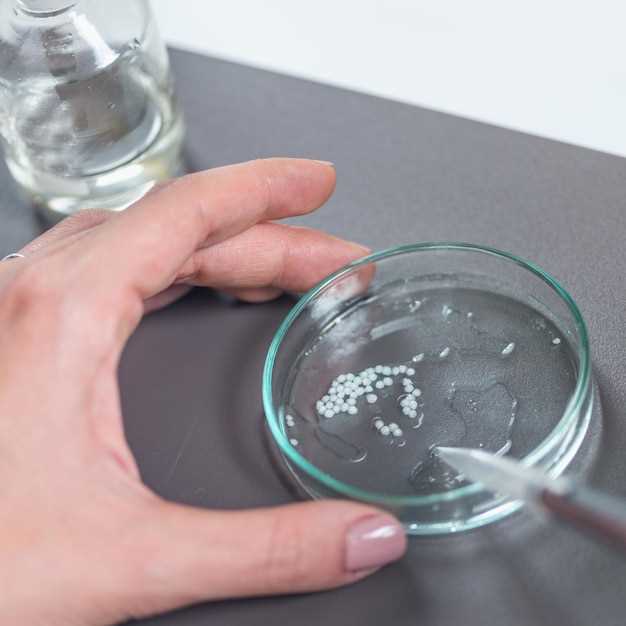
2. Particle size reduction

Water solubility of metformin hydrochloride
2026-03-17Metformin hydrochloride is a commonly used medication for managing type 2 diabetes. Understanding its water solubility is essential for ensuring proper dosing and effectiveness.
With our comprehensive research and testing, we provide accurate information on the water solubility of metformin hydrochloride. Trust us to deliver reliable results that can help optimize your treatment plan.
Don't compromise on quality or accuracy when it comes to your medication. Choose our services for precise data on the water solubility of metformin hydrochloride.
Factors affecting solubility
There are several key factors that can influence the solubility of a drug like metformin hydrochloride in water. Understanding these factors is crucial for optimizing the water solubility of the drug:
- Particle size: Smaller particle sizes typically lead to increased solubility as they provide a larger surface area for interaction with the solvent.
- pH: The pH of the solution can significantly impact the solubility of metformin hydrochloride. Adjusting the pH to the appropriate range can enhance solubility.
- Temperature: Generally, increasing temperature can increase the solubility of a drug in water. However, this relationship can vary depending on the specific drug.
- Presence of co-solvents: Adding co-solvents can improve the solubility of metformin hydrochloride by altering the polarity of the solvent system.
- Crystalline form: The crystalline form of the drug can impact its solubility. Amorphous forms of a drug tend to be more soluble compared to crystalline forms.
By carefully considering and manipulating these factors, it is possible to optimize the water solubility of metformin hydrochloride, leading to improved bioavailability and effectiveness of the drug.
Factors affecting solubility
The solubility of a substance, such as metformin hydrochloride, in water can be influenced by various factors. Understanding these factors is crucial for optimizing the solubility of metformin hydrochloride and enhancing its effectiveness. Some key factors affecting solubility include:
- Temperature: Generally, solubility increases with temperature. Higher temperatures can lead to better dissolution of metformin hydrochloride in water.
- pH: The pH of the solution can impact the solubility of metformin hydrochloride. Adjusting the pH to an optimal range can improve its solubility.
- Solvent: The choice of solvent can significantly affect the solubility of metformin hydrochloride. Selecting the right solvent or solubilizer can enhance dissolution rates.
- Particle size: The particle size of metformin hydrochloride can influence its solubility. Smaller particle sizes can lead to increased surface area, improving solubility.
- Stirring speed: Agitation or stirring can aid in increasing the solubility of metformin hydrochloride by promoting contact between the solid and the solvent.
By considering and controlling these factors, it is possible to enhance the solubility of metformin hydrochloride and achieve better therapeutic outcomes.
Methods for enhancement
Improving the water solubility of metformin hydrochloride is crucial for enhancing its bioavailability and therapeutic effectiveness. Several methods have been developed to increase the solubility of this poorly water-soluble drug. Some of the common methods for enhancement include:
1. Solid dispersion
In this method, the drug is dispersed in a water-soluble carrier to increase its solubility. Solid dispersion can significantly improve the dissolution rate and bioavailability of metformin hydrochloride.
2. Particle size reduction
By reducing the particle size of the drug, its surface area increases, leading to improved solubility. Techniques such as micronization and nanonization are used to reduce the particle size of metformin hydrochloride.
| Method | Description |
|---|---|
| Solid dispersion | Drug dispersed in water-soluble carrier |
| Particle size reduction | Reducing particle size for increased solubility |
These methods offer effective ways to enhance the water solubility of metformin hydrochloride, improving its pharmacokinetic profile and overall therapeutic benefits. By employing these enhancement techniques, the efficacy of metformin hydrochloride can be significantly improved.
Advantages of improved solubility

Improved solubility of metformin hydrochloride offers several benefits in pharmaceutical formulations:
1. Enhanced Bioavailability
Enhanced bioavailability: Higher solubility leads to better dissolution rates and improved absorption in the gastrointestinal tract, resulting in increased bioavailability of the drug in the body.
2. Improved Formulation Flexibility
Improved formulation flexibility: With increased solubility, metformin hydrochloride can be incorporated into a wider range of dosage forms, such as tablets, capsules, and oral solutions, allowing for greater choice in drug delivery methods.
